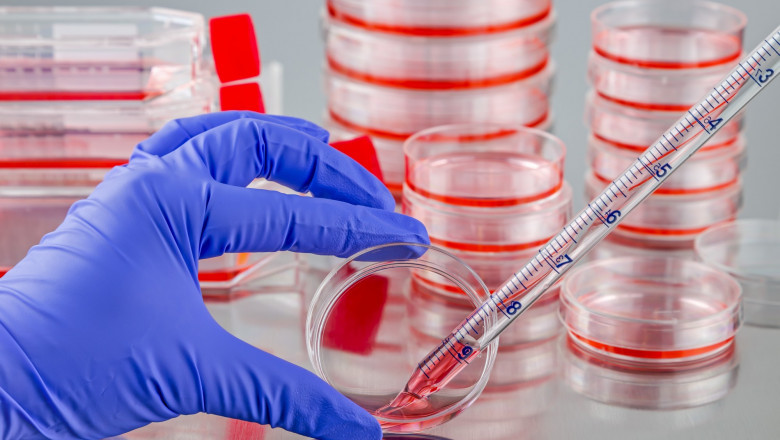

views
Cell culture is the process of growing cells under controlled conditions. Cell tissue culture necessitates the cultivation of a suitable cell or tissue in an appropriate medium under aseptic conditions, as well as the addition of various regulators to maintain cell growth. Strict licence and accreditation procedures, as well as the complexity of cell culture techniques, are limiting growth for Cell And Tissue Culture Supplies.
Various manufacturers in the market have begun to supply serum-free media due to benefits such as nutrient specificity and a lower risk of infection. Though serum-free media is more expensive than serum media, the benefits of the former outweigh the cost in the long run. Disadvantages of serum media include, no defined composition, variation in the results obtained, risk of infections, and reduced specificity, among others.
Read More- https://www.coherentmarketinsights.com/market-insight/cell-and-tissue-culture-supplies-market-3770